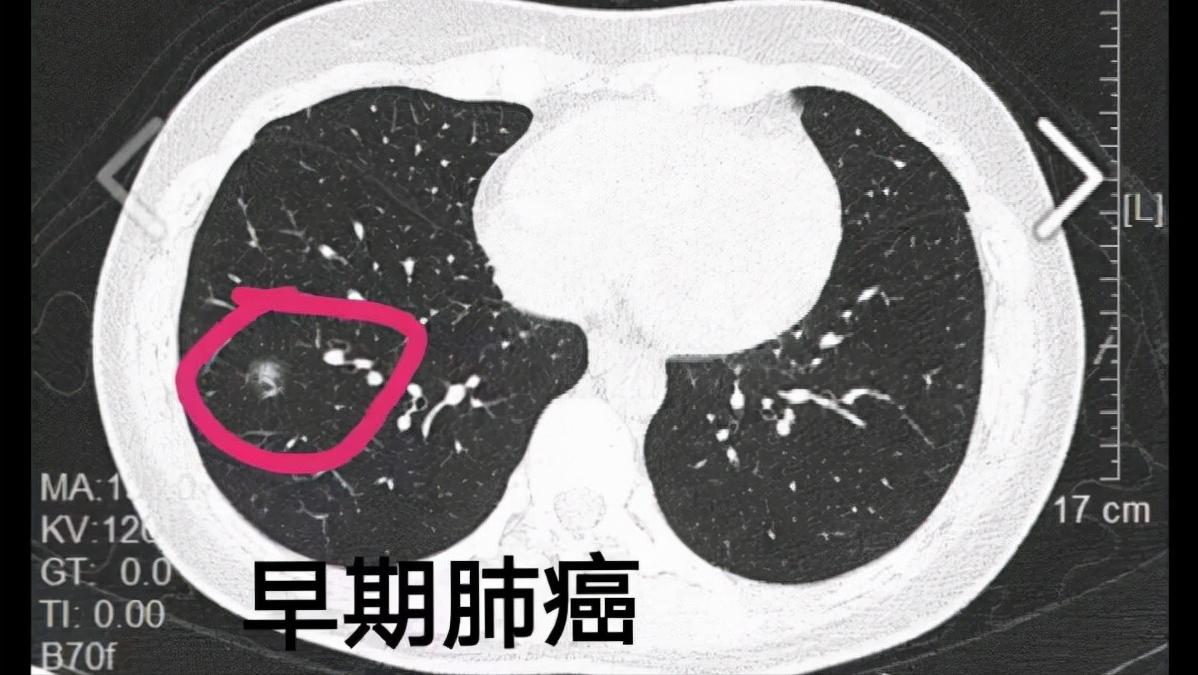
咽喉炎肺会有症状吗,如果咽喉肿痛怎么办

肺部作为机体最大的呼吸器官,它的重要性不言而喻。随着空气质量逐渐下降,以及新冠疫情带来的影响,关注肺部健康成为重中之重。
但是,我们的肺脏是一个比较脆弱的器官,很容易因为各种因素受到伤害。而且,近几年的相关研究报告显示,肺部患病率不断攀升,主要是因为我们的肺部痛觉神经太少了。即便是已经发生了疾病,身体也不会有什么明显的症状。
而等到身体感到异常的时候,此时已经错过了治疗的最佳时机,甚至已经无力回天。所以,这一点大家应该引起重视。
正如下面将要说得当你的咽喉出现这2个症状时,提示肺可能出现问题了。

一、若咽喉出现这2个症状,可能是你的肺在敲警钟!
肺癌因其极高的患病率和致死率,令人们避之不及。因为多数肺癌在确诊时,已经处于中晚期,这时即便病人积极配合医生治疗,预后效果也不乐观。所以对于肺癌来说,早发现早治疗是非常重要的。
根据临床发现,早期肺癌的病人身体上已有部分征兆,例如持续发热、咳嗽、咯血、胸痛等。尤其是喉咙出现以下2个症状,千万不要大意。
咳嗽不止
咳嗽,其实是我们人体的一种反射性的保护机制。当我们肺部吸进异物时,胸腔会突发性地收缩,紧接着使肺内高压的气体喷出,呼吸道内的异物、分泌物等也会随之排出体外。正常情况下,对我们的身体并无损害。但如果咳嗽的剧烈而频繁,影响生活和休息的时候就属于病理性咳嗽,这时候可要注意了。

按照病程时间的长短,咳嗽可分为急性、亚急性、慢性咳嗽。急性咳嗽,指的是在3周之内的咳嗽,也是我们平常就诊时最为常见的一种症状,主要是由支气管炎、肺炎、肺结核等引起。亚急性咳嗽是指处于3周以上8周之内,这种情况背后的病症比较复杂。
而慢性咳嗽则是指8周以上,甚至有可能持续数年或者数十年,其原因包括很多,以咳嗽变异型哮喘和上呼吸道咳嗽综合征最为常见。

如果咳嗽无痰或者痰量甚少,便是我们理解意义上的干咳。干咳一方面可能是由人体周围的环境状况较差引起的,如果我们总是处在难闻的味道或很多粉尘的环境下,很容易对肺部造成伤害,导致干咳症状出现。
另外,也可能是由相关病症引起的,常见于急性咽喉炎、支气管炎、早期肺结核、胸膜炎等,甚至肺癌早期也会出现干咳的症状。

由于咳嗽在我们日常生活中很常见,所以很容易被我们忽视。不过,我们也要分清具体的情况,如果只是因患有感冒、扁桃体发炎或者在特定环境刺激下引发的咳嗽,并不需要担心。但如果长期咳嗽、干咳,并伴有咯血、持续发烧等症状,需要及时就诊。
咽喉肿痛
肺部出现异常除了会引起咳嗽,还会导致喉咙出现异状,最常见的便是喉咙肿痛。有些人认为这仅仅是因为咽喉发炎,但有些时候却是肺癌的表现,这该如何解释呢?

咽喉发炎和肺癌是两种完全不同的疾病,咽喉发炎只是一种良性病变,通常利用药物、雾化等方式进行保守治疗即可改善,而肺癌则是会危及病人性命,多见手术治疗,而且中晚期的肺癌患者还要考虑结合化疗的方式进行治疗。
虽然它们都有咽喉肿痛的表现,但还是大相径庭。咽喉发炎往往伴有反复的咽干、且咽部有明显的异物感,声音嘶哑等症状。而肺癌患者则会出现痰中有血、胸痛的情况,等到了中晚期的时候甚至还会出现全身消瘦的症状。
所以,一定不要简简单单地认定喉咙肿痛就是咽喉发炎。如果发现伴有其他明显的症状,应当及时就医,万不可存在侥幸心理。

二、一旦肺部发生病变时,会带来这些危害!
其实当肺部发生病变时,并不只是以上这2种症状。当肺部疾病发展到一定的阶段,还会给患者的身体带来这些危害。
大家都知道,肺部是进行气体交换的主要场所,但如果肺功能异常的话,就会导致这一过程出现异常,一旦肺功能受损,就会出现缺氧的情况。那么,什么是肺功能受损呢?
通俗来讲,肺气不足就是肺部呼吸能力弱。如果肺部的呼吸功能下降,就会导致肌体从外界获取的氧气较少,呼吸短而浅,久而久之,就会造成肺功能受损,也就是身体从外界获取的氧气不足,从而血氧含量下降,身体进入低氧运作状态。

比如我们熟知的肺部感染,由于肺部发生实变,这部分肺组织就难以恢复其正常功能,而剩下的肺组织又无法完全代偿,引起缺氧。
而且处在我们体内的脑神经元每时每刻需要消耗掉我们体内20%的血氧供给,再加上颅骨内不允许提供额外的空间储存血氧,所以血氧对脑神经元很重要。一旦完全终止供给血氧3-5分钟,脑神经元就会不可逆性死亡。

一旦缺氧损害达到凋亡时,将会继发引起所在组织和器官的功能障碍,比如严重心律失常、肾功能衰竭等等。所以,肺部发生病变也会引发缺氧的情况,对身体造成不可逆的伤害。
另外,肺部病变还可能导致患者出现不同程度的咳嗽咳痰乃至咯血的情况。而且在病变的反复刺激下,还会导致患者的气道发痒、发堵甚至疼痛等常见症状。

最后,肺部病变带来的不利影响不仅仅局限于肺部,还可能会引起其他各个器官组织发生病变。比如肿瘤性疾病因局部压迫、远处转移以及内分泌功能异常等,导致咽喉、淋巴以及甲状腺等功能异常。
综上来看,肺部病变后会给患者造成难以承受和不可逆的伤害,因此这对我们日常保护肺部健康提出了更高要求。其实要保护肺部健康,做好这3步可事半功倍!

三、要想肺部保持健康,平时做好这3步!
1、尽早戒烟
众所周知,*草烟**对于肺部的伤害极高,并且在肺癌的众多致病因素中,吸烟也是“拔得头筹”,这也是男性肺癌患者多于女性的重要原因。所以,要想保护肺部健康,第一步便是要远离*草烟**。吸烟人士需要尽早戒烟,绝不能破罐子破摔。不吸烟者,也需要在日常生活中格外注意,是否经常吸入二手烟,对于这种情况要及时避免,远离有害气体。

2、注意空气质量
除了要避免吸烟或二手烟对于肺部的影响,还需注意我们所在城市的空气是否达标。较差的空气质量,会引起灾害性的天气现象,如雾霾,从而严重损害我们的身体健康。所以如果遇到空气质量显示污染时,一定要减少出行。而且必要情况下,需佩戴口罩,减少空气污染对于肺部的伤害。

3、常做深呼吸
在日常生活中,我们也可以每天早中晚进行三次深呼吸,每次持续时间最好控制在十分钟以上。长期坚持深呼吸的人,能够恢复肺部弹性,也会使肺活量大大增加,可以有效预防或缓解肺部疾病。同时也会降低身体的血压,预防高血压的发生。

重要提示
对于处在肺部疾病高发期的中老年人,需格外注意肺部健康。平时要例行体检,多遵医嘱,控制血糖,健康饮食,注意日常的作息时间。切忌吸烟喝酒,有肺部旧疾的人群,更需额外关注肺部的恢复状况,认真控制好心肺疾病,谨防复发。最后,祝愿大家都可以健健康康,远离肺部疾病!
参考资料:
[1]肺部超声在严重急性低氧性呼吸衰竭中的应用进展[J].临床急诊杂志. 2022,23(02)
[2]吸烟和不吸烟患肺癌差别[J].开卷有益-求医问药. 2021,(09)
[3]肺癌的早期症状和临床分期检查[J].益寿宝典. 2017,(31)
[4]在社区中老年慢性阻塞性肺部疾病康复的探讨[J].中国康复. 1994,(04)